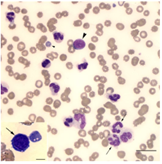

Info
Click on the "Edit" button in the top corner of the screen to edit your slide content.
Discrimination Sensitive
Refers to Atypical lymphocytes (ALY), immature large cells (LIC), and Nucleated Red Blood Cells (NRBC).
It helps doctors to distinguish the quality of the results from competing devices, which improves the accuracy of the diagnosis.
Scope of Results
A wide range of (RBC 0-17) - (HGB 0-250) - (WBC 0 - 300) and (PLT 0 - 4000) results compared to competing
devices of the same model and type, which is good for more accurate and
high-quality results.
Why the Wide Linearity Range is So Important?
In Some Cases Like Acute/Chronic Leukemia, the WBC Could More than 100, the narrow linearity doesn't meet this situation, whereas diluting samples may cause errors. However, the wide linearity can get accurate value directly.
Atypical Chronic Myeloid Leukemia ina Dog.
Atypical Chronic Myeloid Leukemia ina Dog. Chronic Eosinophilic Leukemia in a Cat.
Chronic Eosinophilic Leukemia in a Cat.Improve Accuracy To Assist Insights
31 Parameters and the most important thing in this device is 6 (NLR-PLR-LIC-ALY)
individual parameters wich are superior to the devices in the domestic market.
Do You Know ALY and LIC in Animals ?
 ALYs - ALYs are the Transformation of Lymphocytes Due to the Antigen Action.
ALYs - ALYs are the Transformation of Lymphocytes Due to the Antigen Action. LICs - LICs Generate when Granulocytes have Defects During Maturation. The Nucleus does not Differentiate into Segmented.
LICs - LICs Generate when Granulocytes have Defects During Maturation. The Nucleus does not Differentiate into Segmented.FeLV is one of the most common virus that cats are susceptible, which can cause many fatal diseases. The infection rate is 2%-3% worldwide, even more than 3% in some developed countries[1]. If your pets get FeLV infection, WBC#, LYM#, NEU# will decrease, but the LIC# appears.
Pneumonia is mainly caused by bacteria and virus. When pets get viral or bacterial pneumonia, the infection rate could up to 100%[2].
If there is bacterial pneumonia, WBC# and NEU# will increase and a large number of LIC# appears.
If there is viral pneumonia, LYM% increases but WBC# remains unchanged.
Flow Cytometry + 3D Laser thes method of work is unique and the error rate is almost
zero. It goes through three stages: HS-LS-MS That’s good for accuracy result.

Rating
0
0
There are no comments for now.
Join this Course
to be the first to leave a comment.